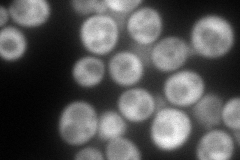
YPL061W
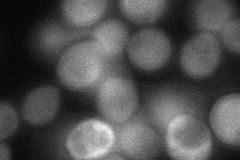
YPL061W
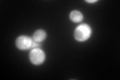
YPL061W

View description
Cytosolic aldehyde dehydrogenase, activated by Mg2+ and utilizes NADP+ as the preferred coenzyme; required for conversion of acetaldehyde to acetate; constitutively expressed; locates to the mitochondrial outer surface upon oxidative stress
Localization:
Intensity:
Fold change:
Significance:
-
C’ GFP library in SD

cytosol2806.67 -
N' NOP1pr-GFP in SD

cytosol119.305 -
N' TEF2pr-mCherry in SD
cytosol164.121 -
N' NATIVEpr-GFP in SD

cytosol585.883 -
N' TEF2pr-VC and Cyto-VN in SD
cytosol65.6975 -
C’ GFP library in SD+DTT

cytosol2161.060.76Yes -
C’ GFP library in SD+H2O2

cytosol2532.760.9No -
C’ GFP library in Starvation Media
cytosol791.060.28Yes -
C’ GFP library on the background of Pup2-DaMP

cytosol -
C’ GFP library on the background of CCT mutant

cytosol2080.950.741429Yes
